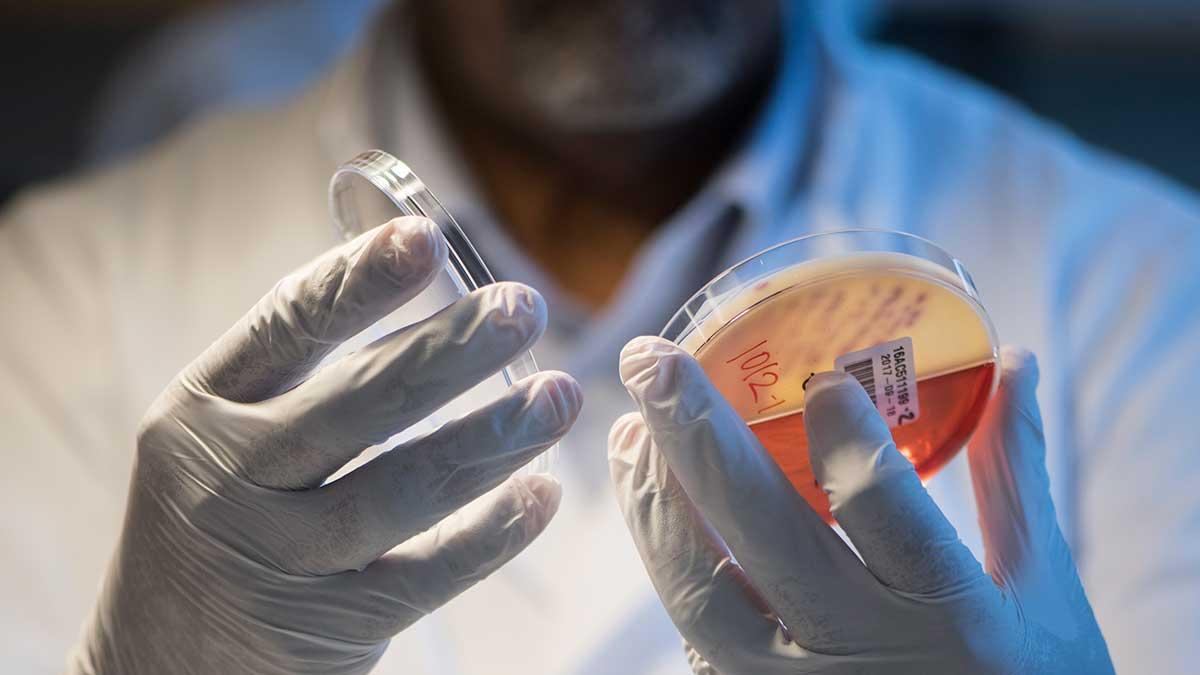

Läkemedelsbolaget Bioinvent har genomfört en riktad emission som tillför bolaget cirka 487 miljoner kronor före transaktionskostnader. Nya investerare som nämns är HBM Healthcare Investments, Swedbank Robur Medica och Invus Public Equities.
Bioinvent tar in 487 miljoner i emission

Emissionen omfattade 352.710 138 nya aktier som såldes för 1,38 kronor styck. Det motsvarar en premie på cirka 3,6 procent mot tio dagars volymvägda genomsnittskurs före och inklusive den 8 juni.
Investerare i emissionen är svenska och internationella institutionella investerare. Nya investerare som nämns är HBM Healthcare Investments, Swedbank Robur Medica och Invus Public Equities. Befintliga aktieägare som deltog är Van Herk Investments, Omega Funds, Fjärde AP-fonden och Handelsbanken Healthcare Fund.
”Tillförda medel kommer att användas för ett flertal milstolpar i närtid och på medellång sikt, inkluderat tidiga resultat från den öppna fas I-studien med BI-1206 i kombination med rituximab i indolent NHL under andra halvåret 2020”, kommenterar vd Martin Welschof.
Utspädningseffekten är cirka 41,3 procent.
Utöver den riktade emissionen avser styrelsen att i juli offentliggöra en icke-garanterad företrädesemission (reparationsemission) på maximalt cirka 146 miljoner kronor. Teckningspriset blir på 1,38 kronor per aktie, det vill säga det samma som i den riktade emissionen. Investerare som deltagit i riktade emissionen kommer inte att delta i det efterföljande erbjudandet.
Läs mer: Bioinvent tar in 64 miljoner








